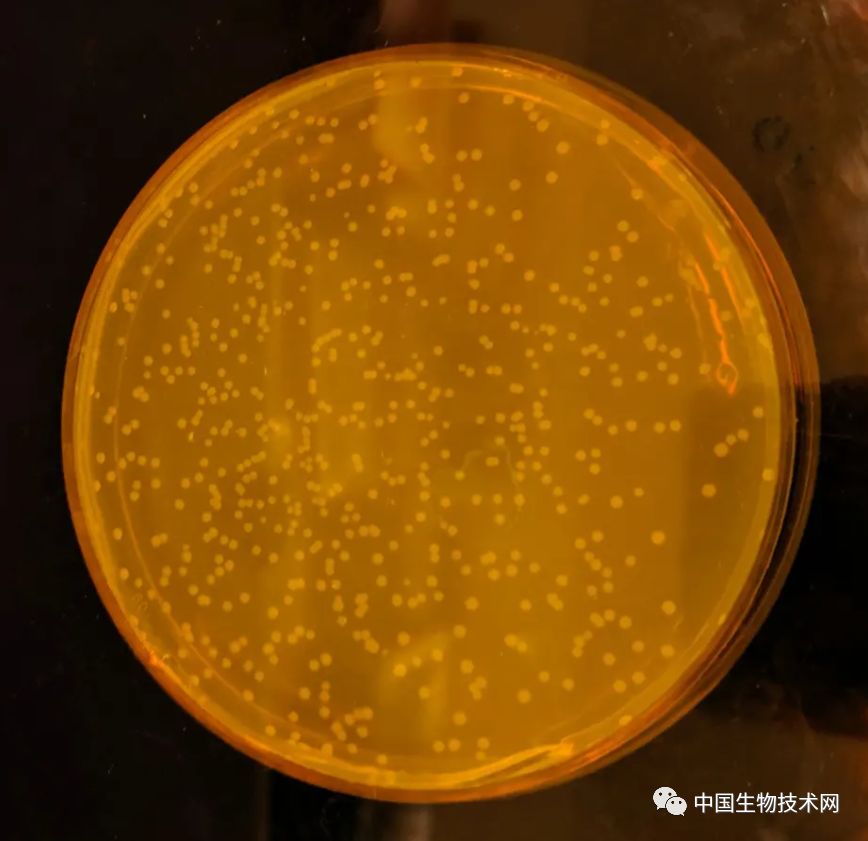
Nature重磅！第一个完全合成且彻底改变DNA密码的生物诞生了

| 原创编译,转载须注明来源!

北京时间5月16日,发表在《Nature》上的一项研究显示,英国剑桥大学的科学家已经在实验室成功创造了世界上第一个完全合成并且彻底改变DNA密码的生命体。它是普遍存在于土壤和人类肠道中的大肠杆菌(Escherichia coli),与其天然*亲近**相似,但依靠一套较小的遗传指令存活。

这种细菌的存在证明,生命可以存在于有限的遗传密码中,并为生物合成药物、材料,或添加病毒抗性等新特性铺平了道路。
剑桥大学分子生物学实验室的研究人员经过两年的努力,读取并重新设计了大肠杆菌的DNA,然后用经过改造基因组的合成版本创建了细胞。
人工基因组包含400万个碱基对,遗传密码由字母G、A、T和C组成。这些碱基对如果全部在A4纸上完整打印,将长达970页。这是迄今为止科学家们构建的最大基因组。
领导该项目的合成生物学专家Jason Chin说:“我们完全不清楚,是否有可能让一个基因组变得如此之大,以及是否有可能对其进行这么大的改变。”
在细胞内盘绕的DNA保存着细胞运作所需的指令。例如,当细胞需要更多的蛋白质来生长时,它会读取编码正确蛋白质的DNA。DNA字母由三个称为密码子的三元组组成,如TCG和TCA。
从水母到人类,几乎所有的生命都使用64个密码子,但他们中的许多都做着同样的工作。总共有61个密码子产生20种天然氨基酸。这些氨基酸可以像串珠一样串在一起,构建出自然界中的各种蛋白质。另外3个密码子实际上是停止信号,它们告诉细胞蛋白质什么时候完成了,就像句子末尾的句号一样。
新的合成生物Escherichia coli Syn61
该研究团队通过移除一些多余的密码子来重新设计大肠杆菌的基因组。他们在计算机上工作时,仔细检查了大肠杆菌的DNA。每当遇到TCG(一种制造丝氨酸的氨基酸密码子)时,他们就把它改写成AGC,以此类推,他们系统地替换了另外两个密码子。

图片来源:《Nature》
在18218次编辑后,科学家们已经从这种细菌的基因组中删除了每一次出现的三个密码子。重新设计的遗传密码随后被化学合成,并被一段段地添加到大肠杆菌中,取代了其天然的基因组。科学家们表示,它是一种具有完全合成和彻底改变的DNA密码的微生物。这种名为Syn61的合成生物比正常体稍长,生长速度也慢一些,但仍然存活了下来。
Chin说:“这真是太不可思议了!当这种细菌在圣诞节前不久被创造出来的时候,研究团队在实验室里拍了一张照片,照片中以一盘微生物为中心人物,重现了耶稣诞生的场景。”
Chin认为,这样的设计生命形式迟早会派上用场。由于它们的DNA不同,入侵的病毒将难以在其体内传播,使它们实际上具有抗病毒的能力。如今,大肠杆菌已被生物制药行业用来制造糖尿病胰岛素和其他治疗癌症、多发性硬化症、心脏病和眼科疾病的药物化合物。但当细菌培养物受到病毒或其他微生物的污染时,整个生产过程可能会遭受到破坏。但这还不是全部,未来的工作中,这些释放出来的遗传密码可能会被重新利用,以使细胞大量生产设计酶、蛋白质和药物。
2010年,美国科学家宣布创造出世界上第一个合成基因组的生物体。这种名为生殖支原体的细菌,其基因组比大肠杆菌要小,大约有100万个碱基对,而且没有进行彻底的重新设计。

图片来源:《Science》
该美国研究团队的Clyde Hutchison在评论这项最新工作时表示,这种基因组置换的规模比迄今报道的任何一个完整的基因组都要大。
伦敦帝国理工学院合成生物学研究员Tom Ellis表示:“这项研究将合成基因组学领域提升到了一个新的水平,不仅成功构建了迄今为止最大的合成基因组,而且编码变化也达到了迄今为止的最高水平。”
但这些纪录可能不会维持太久。 Ellis和其他科学家正在为面包酵母构建一个合成基因组,而哈佛大学的科学家正在制造更多编码变化的细菌基因组。Ellis补充说:“重新设计的大肠杆菌不能像自然菌株那样生长并不令人惊讶。如果说有什么让人叹为观止的,那就是在经历了如此多变化后,它竟然还在增长。”
中国生物技术网诚邀生物领域科学家在我们的平台上,发表和介绍国内外原创的科研成果。
注:国内为原创研究成果或评论、综述,国际为在线发表一个月内的最新成果或综述,字数500字以上,并请提供至少一张图片。投稿者,请将文章发送至weixin@im.ac.cn。
本公众号由中国科学院微生物研究所信息中心承办
微信公众号:中国生物技术网
回复关键词 “ 热点 ”可阅读热点专题文章,包括“施一公”、“肠道菌群”、“肿瘤”、“免疫”和“健康”
近期热文
直接点击文字 即可浏览!
1、补牙或将成为历史?
2、科学你慢慢学,中医我先治病去了
3、科学告诉你应该多久洗一次澡
4、新证据:喝咖啡能延长寿命!
5、据说,这是生物医学硕士博士生的真实的生活写照
6、一顿早餐到底有多重要?
7、情商也是把双刃剑!高情商或让你更脆弱
8、施一公:压死骆驼的最后一根稻草,是鼓励科学家创业!
9、“科学禁食法”真能降低重大疾病风险
10、睡眠科学家揭示出8种睡好觉的秘诀
11、有志者事竟成!2型糖尿病成功被逆转
12、每周两半小时,任何形式的锻炼都可以使你更长寿
13、喝醉以后,你以为睡一觉就没事儿了?!
14、仰卧起坐等或将成为延寿运动?
15、冥想、瑜伽、太极等不仅能够改善身心健康...